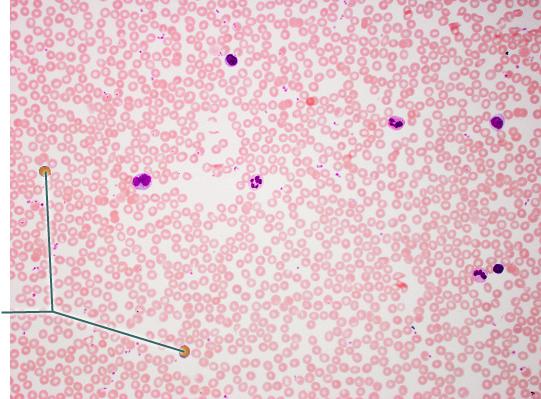

Name H
occipital
frontal
parietal
temporal
occipital

Name E.
sacral
perineal
coxal
inguinal
coxal

Name I
coxal
sacral
perineal
gluteal
sacral

Name B.
frontal
temporal
occipital
cervical
cervical

Name K.
sural
calcaneal
tarsal
crural
calcaneal

Name J.
brachial
popliteal
femoral
sural
popliteal

Name A.
cervical
brachial
occipital
cephalic
cephalic

Name D
sural
crural
brachial
femoral
femoral

Name the region B.
middle hypochondriac
hypogastric
epigastric
Umbilical
Umbilical

Name the region A.
epigastric
umbilical
right hypochondriac
hypogastric
epigastric

Name the region E.
left hypochondriac
right lumbar
epigastric
left iliac
left iliac

Name the region C.
middle iliac
epigastric
umbilical
hypogastric
hypogastric

Name the region D.
Right Hypochondriac
Left Hypochondriac
epigastric
Right Lumbar
Right Hypochondriac

The liver is found in the region labeled:
A

Name the plane D
transverse
parasagittal
midsagittal
oblique
oblique

Name the plane E.
transverse
frontal
oblique
mid saggital
frontal

Name the plane B.
transverse
frontal
para saggital
oblique
para saggital

Name the Plane C
frontal
transverse
sagittal
midsagittal
transverse

Name the plane A
frontal
parasagittal
midsagittal
transverse
midsagittal

Name the cavity A.
dorsal
cranial
vertebral
ventral
cranial

Name the cavity C.
cranial
thoracic
abdominal
pelvic
thoracic

Name the cavity formed by A and B.
abdominopelvic
ventral
dorsal
pelvic
dorsal

Name the cavity formed by D and E.
ventral
abdominopelvic
dorsal
thoracic
abdominopelvic

Name the cavity formed by C, D and E.
dorsal
cranial
ventral
abdominopelvic
ventral

Name the cavity E.
cranial
pelvic
abdominal
thoracic
pelvic

Produces ATP aerobically.
B

Site of synthesis of lipid and steroid molecules.
A

Source of cell autolysis.
C

Site of enzymatic breakdown of phagocytized material.
C

Replicate for cell division.
D

Packages proteins for insertion in the cell membrane or for exocytosis.
E

Name the structure B.
golgi complex
smooth ER
rough ER
mitochondria
rough ER

Name structure A
Lysosome
mitochondria
nucleus
golgi complex
nucleus

Name the structure letter C.
mitochondria
rough ER
smooth ER
golgi complex
golgi complex

Name structure D.
centrioles
mitochondria
lysosome
golgi complex
mitochondria

Name the structure F.
golgi complex
rough ER
smooth ER
mitochondria
smooth ER

Peripheral protein.
E

Identification "tags" for the cell.
A

Polar region of phospholipid.
B

Glycocalyx.
A

Hydrophilic portion of phospholipid.
B

Nonpolar region of phospholipid.
C

Name the phase
metaphase
prophase
interphase
anaphase
prophase

Name the phase
telophase
metaphase
anaphse
prophase
metaphase

In which phase of the cell cycle is the highlighted cell?
interphase
metaphase
prophase
anaphase
prophase

In which phase of the cell cycle is the highlighted cell?
metaphase
prophase
interphase
anaphase
anaphase

Name the phase
metaphase
anaphase
interphase
prophase
Interphase

In which phase of the cell cycle is the highlighted cell?
metaphase
anaphase
prophase
interphase
metaphase

Name the phase
interphase
anaphase
metaphase
telophase
anaphase

Name the phase
metaphase
anaphase
telophase
prophase
telophase
Name the tissue?
areolar
adipose
blood
bone
blood

Which tissue is highlighted?
adipose tissue
reticular connective tissue
dense irregular connective tissue
dense regular connective tissue
dense regular connective tissue

Name the tissue
reticular
nerve
areolar
skeletal muscle
areolar

Which tissue is highlighted?
smooth muscle
cardiac muscle
skeletal muscle
elastic tissue
smooth muscle

Which type of tissue is the highlighted region composed of?
stratum corneum
stratified squamous epithelium, keratinized
stratum spinosum
dermis
stratified squamous epithelium, keratinized

Which epithelial type is highlighted?
simple cuboidal epithelium
pseudostratified columnar epithelium
simple columnar epithelium
simple squamous epithelium
simple columnar epithelium

Which structure is highlighted?
reticular fibers
collagenous trabaculae
lymphocytes
macrophages
reticular fibers

Which structures are highlighted?
cilia
microvilli
goblet cells
nuclei
microvilli

Which component of the connective tissue in this field of view is
highlighted?
chondrocytes
extracellular matrix
lacunae
collagen fibers
extracellular matrix

Which epithelial type is highlighted?
stratified squamous epithelium
transitional epithelium
stratified columnar epithelium
stratified cuboidal epithelium
transitional epithelium

Name the tissue
simple squamous
adipose
reticular
areolar
adipose

Which structures are highlighted?
fascicles
striations
nuclei
fibers
nuclei

Name the tissue?
dense regular
stratified squamous
dense irregular
transtitional
dense irregular

Which structure is highlighted?
simple columnar epithelium
microvilli
lamina propria of villus
villus
simple columnar epithelium

What is secreted by the highlighted cell?
bicarbonate rich juice
hormones
digestive enzyme
mucin
mucin

Which structures are highlighted?
nuclei
skeletal muscle fibers
intercalated discs
striations
striations

Which epithelial type is highlighted?
simple cuboidal epithelium
simple squamous epithelium
stratified squamous epithelium
stratified cuboidal epithelium
simple squamous epithelium

Which structure is highlighted?
stratified squamous epithelium, keratinized
stratified squamous epithelium, non-keratinized
stratified cuboidal epithelium
stratified columnar epithelium
stratified squamous epithelium, keratinized

Name the tissue
fibrocartilage
hyaline cartilage
areolar
elastic cartilage
fibrocartilage

Which structures are highlighted?
intercalated discs
striations
sarcomeres
nuclei
intercalated discs

Which epithelial type is highlighted?
stratified squamous epithelium
transitional epithelium
pseudostratified columnar epithelium
simple columnar epithelium
pseudostratified columnar epithelium

The highlighted fibers are produced by what cell type?
adipocyte
fibroblast
mast cell
macrophage
fibroblast

Name the tissue
simple cubodial
stratified cubodial
simple squamous
stratified squamous
simple cubodial

Which structures are highlighted?
nuclei
simple columnar cells
microvilli
goblet cells
goblet cells

Which structures are highlighted?
goblet cells
pseudostratified columnar epithelium
cilia
microvilli
cilia

Where capillary loops are found.
E

Site of the dermal ridges that produce epidermal ridges on the epidermal surfaces of the fingers.
E

Region that thickens markedly when one gains weight.
B

What is produced by the highlighted structures?
cerumen
semen
sweat
sebum
sweat

Which layer of the skin is highlighted?
papillary layer of dermis
reticular layer of dermis
hypodermis
epidermis
papillary layer of dermis

Which region of the skin is highlighted?
hypodermis
reticular layer of dermis
epidermis
papillary layer of dermis
...

Which structure is highlighted?
papillary layer of dermis
stratum corneum
duct of sudoriferous gland
Meissner's corpuscle
duct of sudoriferous gland

Which structure is highlighted?
matrix
follicle wall
hair shaft
hair root
follicle wall

What is secreted by the highlighted structure?
sebum
mucus
cerumin
sweat
sebum

The outermost surface of the hair is called the ________.
cuticle
cortex
matrix
medulla
cuticle

Which layer of the epidermis is highlighted?
stratum granulosum
stratum spinosum
stratum corneum
stratum basale
stratum spinosum

Which structure is highlighted?
hair papilla
hair root
hair follicle
hair shaft
hair papilla

Which structure is highlighted?
hair shaft
hair root
hair papilla
hair follicle
hair follicle

Which structure is highlighted?
sudoriferous gland
hair bulb
hair root
arrector pili muscle
arrector pili muscle

Which structure is highlighted?
epidermis
hypodermis
reticular layer of dermis
papillary layer of dermis
reticular layer of dermis

Which structure is highlighted?
hair shaft
papilla
hair follicle
hair root
...

Which structures would you expect to find in the highlighted
layer?
adipose tissue only
free nerve endings only
blood vessels, free nerve ending, and receptor cells
blood vessels only
blood vessels, free nerve ending, and receptor cells

Which layer is highlighted?
papillary layer of dermis
hypodermis
reticular layer of dermis
epidermis
hypodermis

Reticular layer of the dermis
C

Hypodermis
D

Epidermis
A

Which structure is highlighted?
hair root
hair bulb
hair follicle
hair shaft
hair bulb

Which region of the skin is highlighted?
epidermis
follicle wall
dermis
stratum corneum
...

Which layer is highlighted?
stratum granulosum
stratum spinosum
stratum basale
stratum lucidum
stratum spinosum

Which structure is highlighted?
hair shaft
hair follicle
hair root
hair bulb
hair root

Integral protein
D

Forms the mitotic spindle
D